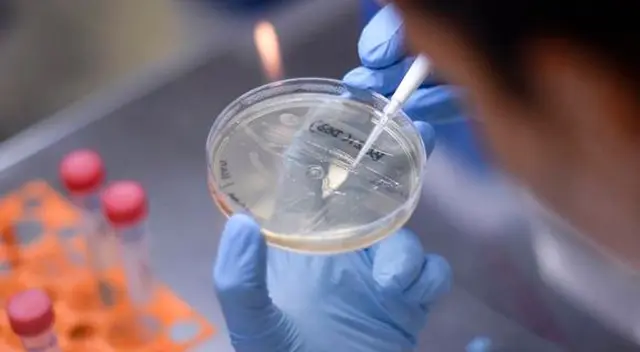
El paciente corresponde a un hombre de 40 años y comenzó con síntomas a principios de abril.

México detecta primer caso de variante del coronavirus de India [VIDEO]
San Luis Potosí es el primer estado en México donde se registra la variante B1-617, responsable del aumento exponencial de casos de coronavirus en India.
Únete al canal de Whatsapp de El Popular- Confirmado | Exigen el retiro urgente de este pescado de los supermercados por ser un riesgo mortal para la población
- ALARMA en Walmart: ICE se burló y arrestó a padre de familia que huyó de la guerra de Ucrania hacia EE.UU.
Este domingo 2 de mayo, San Luis Potosí identificó el primer caso positivo en México de la variante del coronavirus de India, que ha dejado miles de contagios y muertes en el país asiático, según informó la Secretaría de Salud Estatal.
El el secretario de Salud Pública, Miguel Ángel Luztow indicó que la variante se identificó tras una investigación genómica que se realiza en conjunto con las autoridades de Salud federal, a través de los laboratorios del Instituto de Diagnóstico y Referencia Epidemiológicos (InDRE).
"El InDRE nos notificó tres nuevos aislamientos, en tres muestras se identificaron variantes, dos de ellas sin importancia y una que es de interés y justo es la B1-617 que originalmente se le conoce, mal llamada, como variante de la India", indicó el secretario estatal.
PUEDES VER: Pfizer confirma que vacunas contra la COVID-19 que se vendían en México y Polonia eran falsas
La variante B1-617, identificada por primera vez en octubre de 2020, contiene una mutación que permite que el virus se propague más rápido y es la que actualmente provoca el aumento exponencial de casos de coronavirus en India.
“Es la primera vez que ésta variante se identifica en nuestro país y se aisló a partir de una muestra de una persona que reside en la capital del estado”, agregó Luztow.
El paciente corresponde a un hombre de 40 años y comenzó con síntomas a principios de abril. Según los reportes, tuvo contacto con personas que habían viajado a Estados Unidos, país donde también circula esta variante de India.
El paciente se encuentra recuperándose en su domicilio, después de haber permanecido hospitalizado por neumonía.
Luztow exhortó a los ciudadanos que refuercen las medidas preventivas, incluso aquellas personas que han sido vacunadas. Es importante mencionar que San Luis Potosí se mantiene en semáforo amarillo desde hace seis semanas.
Revisa todas las noticias escritas por el staff de redactores de El Popular.











